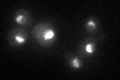
YJR041C
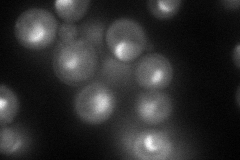
YJR041C
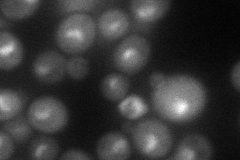
YJR041C
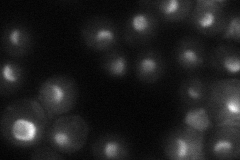
YJR041C
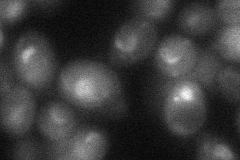
YJR041C

View description
Nucleolar protein required for normal metabolism of the rRNA primary transcript, proposed to be involved in ribosome biogenesis
Localization:
Intensity:
Fold change:
Significance:
-
C’ GFP library in SD
nucleolus42.18 -
N' NOP1pr-GFP in SD
nucleolus93.1436 -
N' TEF2pr-mCherry in SD
nucleolus58.1451 -
N' NATIVEpr-GFP in SD
nucleolus45.46 -
N' TEF2pr-VC and Cyto-VN in SD
nucleolus38.1259 -
C’ GFP library in SD+DTT

nucleolus33.530.79No -
C’ GFP library in SD+H2O2

nucleolus44.821.06No -
C’ GFP library in Starvation Media

nucleolus25.10.59Yes -
C’ GFP library on the background of Pup2-DaMP

nucleolus -
C’ GFP library on the background of CCT mutant

nucleolus44.99731.06651No
